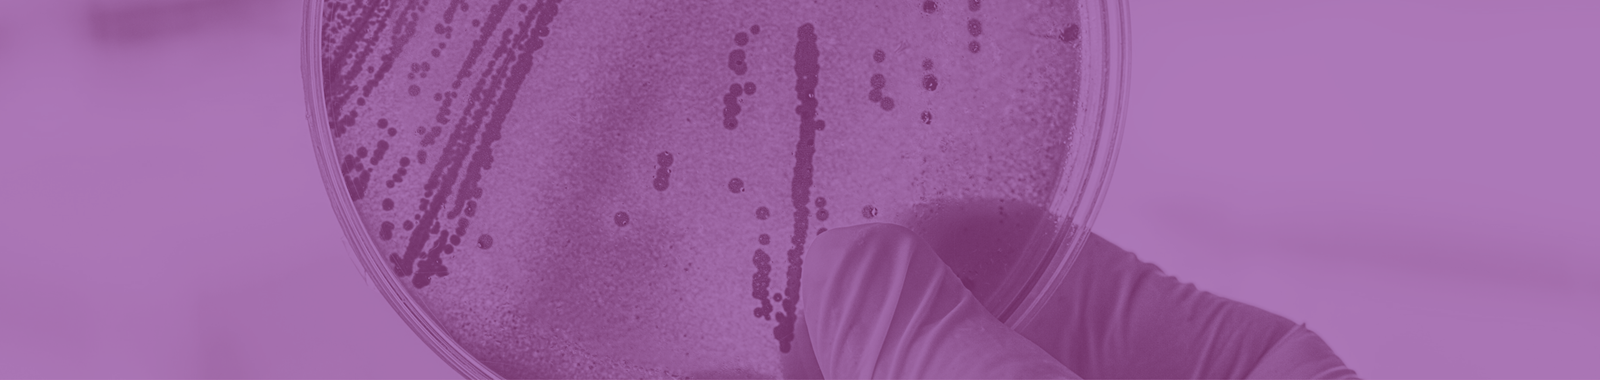
Understanding Risks from Botulinum in Foods

Search >>
Understanding Risks from Botulinum in Foods
Contact us- The organism Clostridium botulinum
- The illness botulism
- Infant botulism
- Types and conditions for growth and survival
- Foods most commonly associated with outbreaks
- Relevance of packaging characteristics
- Toxin production
- Legal requirements and guidance
- Detection
- Historical cases and recalls, with lessons to be learned
- Controls
- Impact on safe shelf-life
- The ’10-day rule’
- Resources
- Technical Managers
- Quality Managers
- Technical and Quality team members
- New Product Development Specialists
- Food Safety Specialists
- Auditors and others seeking a refresher
- Development of microbiological and food safety management expertise
- Understanding of a food safety hazard relevant to a wide variety of jarred / canned, hot-filled, MAP and Vacuum-Packed foods
- Opportunities to ask our expert your own questions
It is recommended that delegates have attended our Introduction to Microbiological Sampling and Testing of Foods course or already have some basic microbiology knowledge through other qualifications such as level 3 HACCP or Food Safety.
Ali Aitchison | Senior Food Safety Consultant | Eurofins Food Testing UK Ltd.